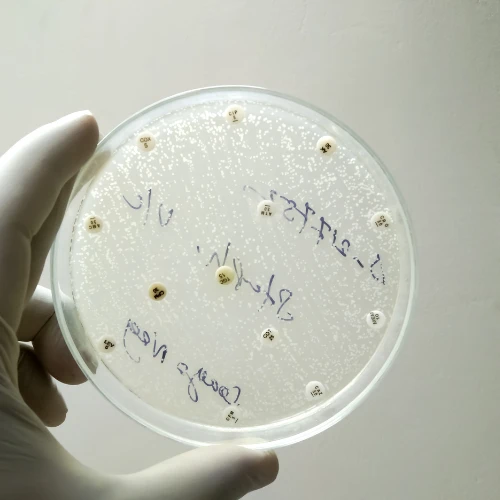
Imagen de: KOH (HONGOS)

Servicios
Descripción
El hidróxido de potasio (KOH) es una solución utilizada en el laboratorio para realizar pruebas de diagnóstico de infecciones fúngicas en la piel, las uñas y las mucosas. En la prueba de KOH, se toma una muestra de la piel afectada y se coloca en una gota de KOH en un portaobjetos. El KOH ayuda a disolver las células de la piel, dejando expuestas las estructuras fúngicas, como las hifas y las esporas. Esto facilita la visualización de los hongos bajo el microscopio y ayuda en el diagnóstico de infecciones fúngicas, como la tiña, la candidiasis y la dermatofitosis. La prueba de KOH es rápida, sencilla y económica, y es una herramienta útil en el diagnóstico de infecciones fúngicas superficiales.
Indicaciones

Quimoto Análisis Clínicos
Quimoto Análisis Clínicos